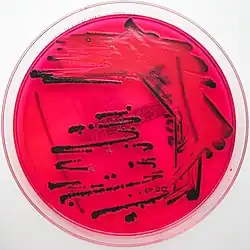

Сальмонеллёзы
| Сальмонеллёз | |
|---|---|
![]() Salmonella typhimurium | |
| МКБ-10 | A02.0 |
| МКБ-10-КМ | A02.0, A01.4, A01.3, A02.2, A01.2, A01.1, A01.0, A02.9, A02.1 и A02.8 |
| МКБ-9 | 003.0 |
| МКБ-9-КМ | 003.0[1][2] |
| DiseasesDB | 11765 |
| MedlinePlus | 000294 |
| MeSH | D012480 |
Сальмонеллёз (лат. salmonellosis) — острая кишечная инфекция животных и человека, вызываемая кишечными бактериями рода сальмонеллы семейства энтеробактерии; острое антропозоонозное инфекционное заболевание, вызываемое сальмонеллами и характеризующееся, преимущественно, развитием интоксикации и поражением желудочно-кишечного тракта.
Клиническая картина
Источником инфицирования сальмонеллёза могут являться животные и люди, при этом роль животных в эпидемиологии является основной.
Механизм передачи инфекции — фекально-оральный. Основной путь передачи инфекции — пищевой[3], главным образом, через продукты животного происхождения, инфицированные сальмонеллами.
Инкубационный период колеблется от 6 часов до 3 суток, составляя в среднем 12—24 часа.
Симптомы заболевания могут быть выражены ярко, а могут и никак не проявляться. В последнем случае человек является источником заражения для окружающих, но сам не страдает (бактерионосительство).
Сальмонеллы поселяются в тонком кишечнике и колонизируют стенку кишки, выделяя экзотоксины. Действие токсинов заключается в потере воды через кишечник, нарушении тонуса сосудов, повреждении нервной системы.
При развёрнутых формах сальмонеллёза в большинстве случаев отмечаются (более или менее выражены) следующие симптомы: повышение температуры тела, общая слабость, головная боль, тошнота, рвота, боли в животе, многократный жидкий водянистый стул.
При тяжёлом течении болезни наблюдаются обезвоживание организма, увеличение печени и селезёнки. Возможно развитие почечной недостаточности. В редких случаях наступает смерть.
Лечение
Основой лечения генерализованной формы сальмонеллёза являются антибактериальные препараты (антибиотики)[4], действующие на грамотрицательные микроорганизмы — полусинтетические пенициллины, фторхинолоны и некоторые другие.
Применяют сочетания антибиотиков группы аминогликозидов (гентамицина сульфат, сизомицина сульфат, амикацина сульфат, тобрамицин и др.) и хинолонов (ципрофлоксацин, офлоксацин и др.), цефалоспорины, левомицетин, ампициллин, амоксициллин[3]. При правильном и своевременном лечении антибиотиками заболевание проходит примерно на десятый день.
Применение тетрациклинов (доксициклин), аминогликозидов, ко-тримоксазола, хлорамфеникола и ранних β-лактамных антибиотиков часто бывает нецелесообразно из-за высокого уровня антибиотикорезистентности у сальмонелл.
При гастроинтестинальной (локализованной) форме сальмонеллёза антибиотики и другие этиотропные препараты не назначаются[4].
Без антибиотикотерапии выздоровление часто происходит за 7—10 дней, однако нередко сальмонеллёз переходит в хроническую форму или бактерионосительство. Носитель, как правило, не ощущает каких-либо симптомов, но способен заражать других.
Одним из альтернативных приёму антибиотиков методов антибактериальной терапии является применение лечебных сальмонеллёзных бактериофагов[4].
Сорбенты используются у пациентов с сальмонеллёзом любой степени тяжести и форм заболевания. Прямое действие адсорбирующих кишечных препаратов направлено на связывание и элиминацию из ЖКТ токсичных продуктов обмена и воспалительного процессе.[5]
Диагностика
Диагностика сальмонеллёза осуществляется комплексно с учётом эпидемиологических данных, симптоматики и результатов лабораторных исследований, направленных на изоляцию и типирование возбудителя. Основным способом типирования сальмонелл является реакция непрямой (пассивной) гемагглютинации (РНГА, РПГА)[3][6].
Эпидемиология
Согласно данным отчета The European Union One Health 2022 Zoonoses Report, сальмонеллез был вторым наиболее часто регистрируемым пищевым желудочно-кишечным заболеванием людей в ЕС в 2022 году. В 2022 году было зарегистрировано 65 208 подтвержденных случаев сальмонеллеза, что соответствует уровню заболеваемости 15.3 на 100 000 населения. Доля госпитализированных случаев составила 38,9 %, уровень смертности — 0,22 %[7].
Топ-5 серотипов Salmonella, вызывающих инфекции у людей: S. Enteritidis (67.3 %), S. Typhimurium (13.1 %), монофазный S. Typhimurium (4.3 %), S. Infantis (2.3 %) и S. Derby (0.89 %). 0,16 % проб готовых к употреблению продуктов и 2,1 % проб продуктов, требующих обработки, были положительными на Salmonella[7].
Крупнейшие эпидемии
- В 2008-2009 в США годах произошла крупнейшая вспышка сальмонеллеза, связанная со сливочным арахисовым маслом марки King Nut, в результате которой заболели 714 человек и девять скончались. В 2012 году была зафиксирована еще одна вспышка, когда 42 человека заразились сальмонеллой через арахисовое масло Trader Joe's, произведенное компанией Sunland.
- 2022, США/Канада. Заражение лука[уточнить] сальмонеллой: Более 1000 заболевших.
Сальмонеллёз у животных
У животных сальмонеллёз встречается в форме клинически выраженного заболевания и бактериовыделительства. Эпидемиологическую опасность представляет инфицирование крупного рогатого скота, свиней, овец, лошадей, собак, кошек, домовых грызунов. Значительное место в эпидемиологии сальмонеллёза занимают птицы. Сальмонеллы обнаруживают в яйцах, мясе и внутренних органах птиц[3].
Микроорганизмы, попадая в организм животных с кормом или другим путём, вызывают в кишечнике воспалительные процессы, которые обусловливают проникновение возбудителя в кровь и лимфу, и разносятся по всему организму, способствуя развитию септицемии. Микробы и их токсины, циркулируя в крови, вызывают глубокие нарушения в паренхиматозных органах вплоть до образования в них некротических процессов. Последние локализуются в печени, селезёнке, почках, лёгких и суставах[8].
Примечания
- ↑ Disease Ontology (англ.) — 2016.
- ↑ Monarch Disease Ontology release 2018-06-29 — 2018-06-29 — 2018.
- ↑ 1 2 3 4 Сальмонеллёзная септицемия (A02.1) (также сальмонеллёзный сепсис, генерализованная форма сальмонеллёза, Salmonella sepsis). Информация об инфекционном заболевании. Справочник заболеваний «MedElement» // diseases.medelement.com. Дата обращения: 5 апреля 2020. Архивировано 18 сентября 2020 года.
- ↑ 1 2 3 Сальмонеллёз: причины, патогенез, симптомы, диагностика, лечение и профилактика заболевания. Архивная копия от 26 ноября 2020 на Wayback Machine // eurolab-portal.ru. Дата обращения: 28 марта 2021.
- ↑ Некоммерческое партнерство "Национальное научное общество инфекционистов". "Клинические рекомендации "Сальмонеллез у взрослых" (одобрены Минздравом России). ЗАКОНЫ, КОДЕКСЫ И НОРМАТИВНО-ПРАВОВЫЕ АКТЫ РОССИЙСКОЙ ФЕДЕРАЦИИ. МИНИСТЕРСТВО ЗДРАВООХРАНЕНИЯ РОССИЙСКОЙ ФЕДЕРАЦИИ (2021).
- ↑ С. Ш. Рожнова, А. Т. Подколзин. МУ 4.2.2723—10. Лабораторная диагностика сальмонеллёзов, обнаружение сальмонелл в пищевых продуктах и объектах окружающей среды. ФБУН «ЦНИИ эпидемиологии» Роспотребнадзора // rospotrebnadzor.ru (13 августа 2010). Дата обращения: 5 апреля 2020. Архивировано 15 июня 2021 года.
- ↑ 1 2 European Food Safety Authority (EFSA), European Centre for Disease Prevention and Control (ECDC). The European Union One Health 2022 Zoonoses Report // EFSA Journal. — 2023-12. — Т. 21, вып. 12. — doi:10.2903/j.efsa.2023.8442.
- ↑ А. В. Жаров, В. П. Шишков и др. Патологическая анатомия сельскохозяйственных животных. — М.: «Колос», 1995. — 543 с.
Литература
- Сальмонеллёзы / В. И. Покровский, Н. Д. Ющук // Большая советская энциклопедия : [в 30 т.] / гл. ред. А. М. Прохоров. — 3-е изд. — М. : Советская энциклопедия, 1969—1978.


.png)